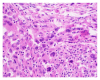
Figure 3

Primary pulmonary malignant fibrous histiocytoma
- PMID: 25838959
- PMCID: PMC4370101
- DOI: 10.1155/2015/381276
Primary pulmonary malignant fibrous histiocytoma
Abstract
Malignant fibrous histiocytoma (MFH) is one of the most common adult soft tissue sarcomas. MFH is very aggressive and is most often found in the extremities and the retroperitoneum, but it can manifest at other sites. Though the lungs are the most common sites of metastasis, they rarely present there as a primary tumor. Our report describes a rare case of a primary MFH tumor in the lung. Careful diagnostic procedure should be followed to ensure the tumor does not have extrapulmonary origins. Though MFH is highly invasive and deadly, surgical excision of the tumor has been shown to be successful.
Figures

References
LinkOut - more resources
Full Text Sources
Other Literature Sources

